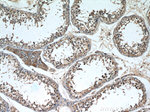
NCALD Antibody in Immunohistochemistry (Paraffin) (IHC (P))

Search
Proteintech
NCALD Monoclonal Antibody (6B4E10)
{{$productOrderCtrl.translations['antibody.pdp.commerceCard.promotion.promotions']}}
{{$productOrderCtrl.translations['antibody.pdp.commerceCard.promotion.viewpromo']}}
{{$productOrderCtrl.translations['antibody.pdp.commerceCard.promotion.promocode']}}: {{promo.promoCode}} {{promo.promoTitle}} {{promo.promoDescription}}. {{$productOrderCtrl.translations['antibody.pdp.commerceCard.promotion.learnmore']}}
产品信息
66088-1-IG
种属反应
宿主/亚型
分类
类型
克隆号
抗原
偶联物
形式
浓度
规格
纯化类型
保存液
内含物
保存条件
运输条件
产品详细信息
This antibody is specific to NCALD.
Immunogen sequence: MGKQNSKLR PEVMQDLLES TDFTEHEIQE WYKGFLRDCP SGHLSMEEFK KIYGNFFPYG DASKFAEHVF RTFDANGDGT IDFREFIIAL SVTSRGKLEQ KLKWAFSMYD LDGNGYISKA EMLEIVQAIY KMVSSVMKMP EDESTPEKRT EKIFRQMDTN RDGKLSMEEF IRGAKSDPSI VRLLQCDPSS AGQF (1-193 aa encoded by BC036098)
靶标信息
This gene encodes a member of the neuronal calcium sensor (NCS) family of calcium-binding proteins. The protein contains an N-terminal myristoylation signal and four EF-hand calcium binding loops. The protein is cytosolic at resting calcium levels; however, elevated intracellular calcium levels induce a conformational change that exposes the myristoyl group, resulting in protein association with membranes and partial co-localization with the perinuclear trans-golgi network. The protein is thought to be a regulator of G protein-coupled receptor signal transduction. Several alternatively spliced variants of this gene have been determined, all of which encode the same protein; additional variants may exist but their biological validity has not been determined.
仅用于科研。不用于诊断过程。未经明确授权不得转售。
篇参考文献 (0)
生物信息学
蛋白别名: Neurocalcin-delta; unnamed protein product
基因别名: AI848120; D030020D09Rik; D15Ertd412e; NCALD
UniProt ID: (Human) P61601, (Rat) Q5PQN0, (Mouse) Q91X97
Entrez Gene ID: (Pig) 100156785, (Human) 83988, (Rat) 553106, (Mouse) 52589